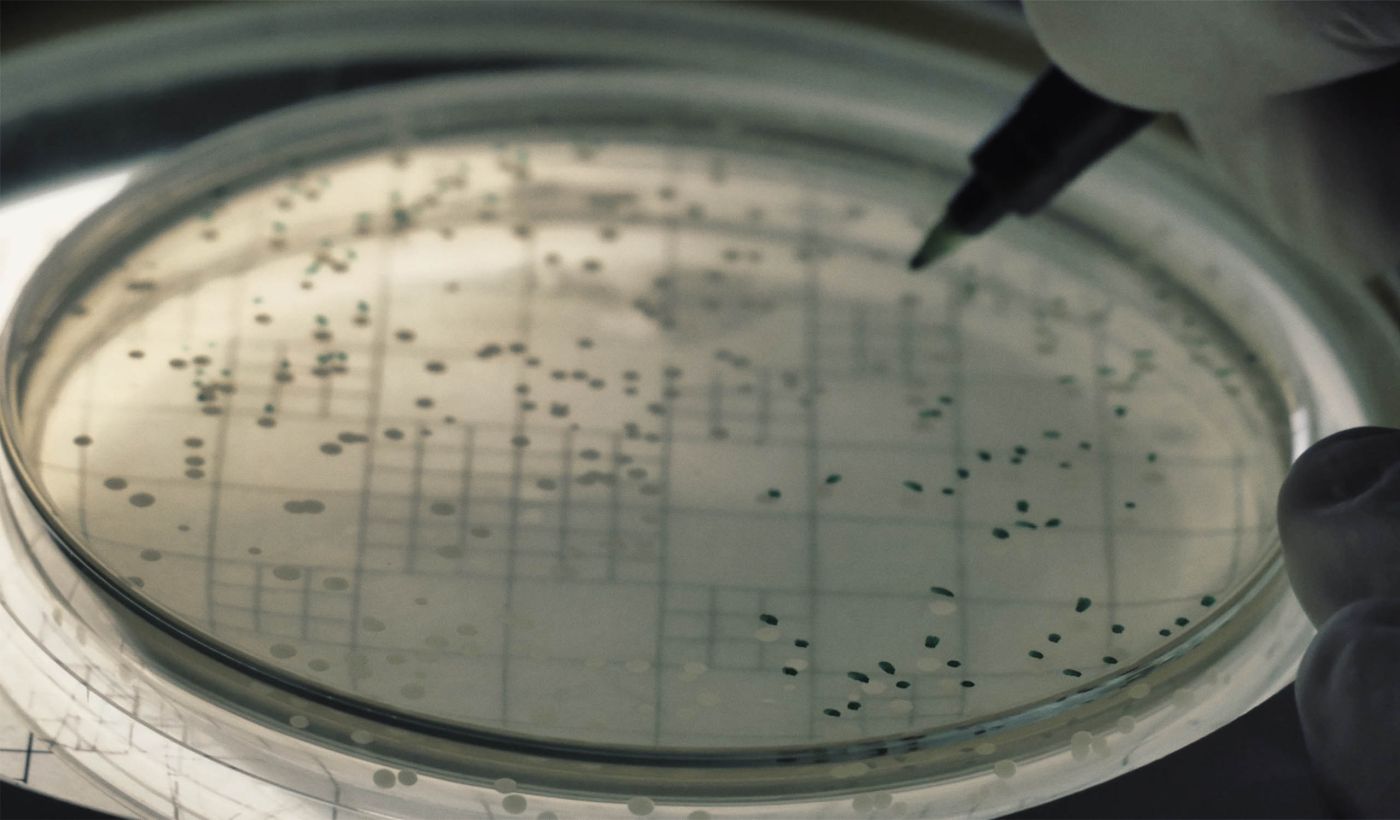

Sobre el proyecto
La ciencia nos permite entender el océano como regulador del clima global y sus amenazas. Con nuestras acciones, podemos mejorar la salud planetaria y garantizar un futuro en equilibrio.
La vida comenzó en los océanos. Los océanos cubren la mayor parte de la superficie de la Tierra y son el mayor ecosistema del planeta. Miles de millones de personas viven en zonas costeras y dependen del funcionamiento físico, químico y biológico de este sistema medioambiental para vivir.
Por desgracia, las actividades humanas están poniendo en grave peligro la salud de los océanos en todo el planeta. Se requieren profundas adaptaciones en nuestros estilos de vida y comportamientos. Por lo tanto, el reto es conseguir que los ciudadanos se sumen y logren un compromiso significativo para apoyar las políticas y actuar de manera que estos cambios puedan producirse. La concienciación y la comprensión de las cuestiones relacionadas con los océanos es un requisito previo para el desarrollo de la ciudadanía oceánica.
Por lo tanto, es fundamental concienciar sobre la riqueza e importancia de los ecosistemas marinos, los retos a los que se enfrentan estos ecosistemas y lo que nosotros, como ciudadanos del mundo, podemos hacer para mejorarlos y preservarlos a través de nuestras decisiones personales.
EL OBJETIVO
Con el proyecto MCSA sobre la Noche Europea de los Investigadores "OceanNight" pretendemos contribuir a afrontar este reto promoviendo la investigación marina y destacando su importancia para lograr una interacción sostenible entre la sociedad humana y el ecosistema marino.
OceanNight es una propuesta multicéntrica que pretende promover la importancia del ecosistema marino. El objetivo principal es aumentar el interés, la concienciación y la comprensión de la ciencia marina. La metodología general se basa en una combinación de diferentes elementos (mensajes clave, temas, formatos, etc.) que garantiza una amplia gama de intervenciones de comunicación científica equilibrada, capaz de llegar a todo el público objetivo pertinente con los temas, medios y mecanismos adecuados. El principio principal es que el ecosistema marino es fundamental para la sociedad humana y el planeta en general, y actualmente se enfrenta a retos críticos que sólo pueden abordarse a nivel social.
EL MENSAJE
Los entornos y ecosistemas marinos son fundamentales para el bienestar de la sociedad humana y de todo el planeta.
La ciencia nos ayuda a comprender su funcionamiento y sus principales amenazas.
Con nuestras acciones podemos mejorar su salud y garantizar su conservación para el futuro.
Las decisiones personales que tomamos cada día se basan en nuestra visión del mundo. Para darle forma, creemos que es importante promover la ciencia y la ingeniería no sólo desde una perspectiva utilitaria, sino también para aumentar la comprensión general de la naturaleza en toda la sociedad y promover una mentalidad lógica para abordar el mundo que nos rodea.
Dentro de esta perspectiva, con OceanNight también pretendemos transmitir los siguientes mensajes:
- España cuenta con numerosos e importantes centros de investigación marina, y su trabajo tiene un importante impacto social y científico;
- La investigación en Ciencias del Mar es apasionante y altamente interdisciplinar, y puede ser una opción profesional muy satisfactoria para personas con un espectro de intereses muy diverso;
- Una carrera en Ciencias del Mar -y en STEM en general- es accesible independientemente del género, la etnia u otras características protegidas;
- La ciencia puede contribuir a mejorar el bienestar y la salud de la sociedad;
- La Unión Europea tiene un papel destacado en la promoción de la ciencia y la educación científica en todo el bloque.
ADENTRÁNDONOS EN EL OCÉANO
EL EQUIPO
OceanNight está formado por todos los principales Centros de Investigación del CSIC (Consejo Superior de Investigaciones Científicas) con un fuerte enfoque en la investigación relacionada con los ambientes marinos y costeros.
Con un total de más de 150 científicos permanentes y varios centenares de ESRs, la investigación realizada en este consorcio abarca los aspectos físicos, químicos y biológicos de los ecosistemas marinos, a través de escalas que van desde lo microscópico (por ejemplo, virus marinos, microalgas, etc.) hasta la escala planetaria global (por ejemplo, interacciones entre los océanos y el clima). Esto incluye también la investigación centrada en el uso sostenible de los recursos naturales marinos. Los científicos de los institutos proceden de una amplia gama de disciplinas, como la microbiología ambiental, la biofísica microbiana, la biología marina, la biogeoquímica, la algología, la ecología marina, la ictiología, la oceanografía física y de ecosistemas y la dinámica de poblaciones. En general, como consorcio disponemos de un sustrato excepcional de conocimientos técnicos a la vanguardia del conocimiento científico en todos los temas principales de OceanNight.
RESULTADOS
Documentos descargables de nuestros avances

Informe sobre las actividades en Colegios para el curso 2021-2022.
“¿Te gusta la ciencia y tienes
preguntas sin responder?”
Nombre del proyecto: "Ocean Night: helping society understand the importance of the marine ecosystem"
Aviso Legal
Política de Privacidad
Uso de Cookies
Enlaces de Interés
Esta dirección de correo electrónico está siendo protegida contra los robots de spam. Necesita tener JavaScript habilitado para poder verlo.